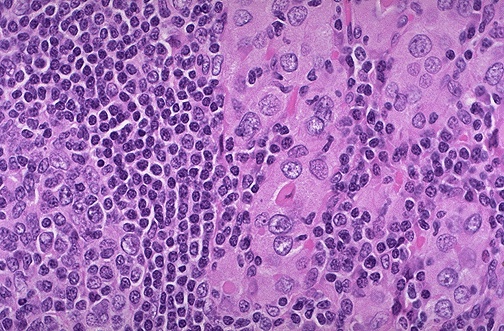

| This high power microscopic view of thyroid with Hashimoto thyroiditis demonstrates the pink Hürthle cells at the center and right. A lymphoid follicle is at the left. Hashimoto thyroiditis initially leads to painless enlargement of the thyroid, followed by progressive atrophy over following years. Aside from surgery, this is the most common cause for hypothyroidism in adults. |
![]() |